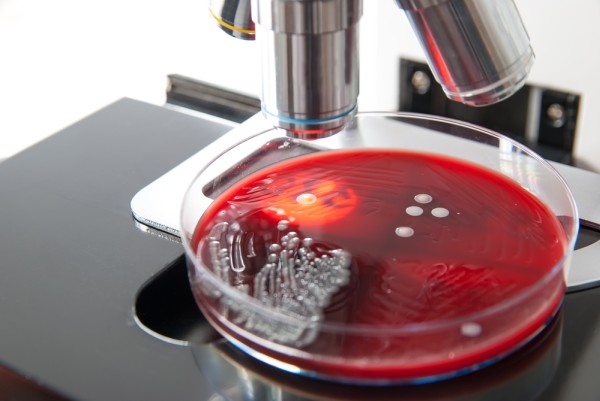

ОБЩИЕ СВЕДЕНИЯ
В природе существует более 27 видов стафилококков. Большинство из них безопасны для человека. Однако особое внимание следует уделить золотистому стафилококку, который является одной из главных причин гнойно-септических заболеваний у людей всех возрастов.
Врачи отмечают, что золотистый стафилококк является одним из наиболее распространенных патогенов, способных вызывать разнообразные инфекции у человека. Специалисты подчеркивают, что этот микроорганизм может обитать на коже и слизистых оболочках здоровых людей, однако при ослаблении иммунной системы или наличии повреждений кожи он может стать причиной серьезных заболеваний. Врачи предупреждают о важности своевременной диагностики и лечения инфекций, вызванных стафилококком, так как некоторые штаммы, такие как MRSA, обладают устойчивостью к антибиотикам. Профилактика, включая соблюдение гигиенических норм и вакцинацию, также играет ключевую роль в борьбе с этим микроорганизмом. В целом, медицинское сообщество настоятельно рекомендует повышать осведомленность о рисках, связанных с золотистым стафилококком, и активно заниматься профилактикой инфекций.

Факты о золотистом стафилококке:
Золотистый стафилококк (Staphylococcus aureus; S. aureus) — грамположительная бактерия сферической или овальной формы, относящаяся к факультативным анаэробам.
Этот вид стафилококков является наиболее патогенным для человека. Он отличается высокой устойчивостью к неблагоприятным условиям окружающей среды и не образует спор в качестве защитной реакции. Бактерия хорошо переносит высушивание, нагрев до 150 градусов, а также воздействие этилового спирта и перекиси водорода.
Золотистый стафилококк может выживать в гипертонических растворах натрия хлорида, что позволяет ему обитать в потовых железах человека. Однако он уязвим к анилиновым красителям, таким как «зеленка».
Эта бактерия производит фермент липазу, растворяющую сальные пробки в устьях волосяных фолликулов. Это объясняет почти 100% вероятность обнаружения стафилококка при микробиологическом исследовании и проявление его симптомов на коже, таких как фурункулы, акне и ячмени.
Фермент коагулаза, вырабатываемый исключительно золотистым стафилококком, способствует образованию микротромбов в сосудистой системе и защищает бактерию от иммунных факторов человека. В таком состоянии микробы могут проникать в различные органы и системы организма.
Золотистый стафилококк производит мощные токсины, вызывающие серьезные пищевые отравления, синдром токсического шока (СТШ) и некоторые кожные поражения у новорожденных.
Тем не менее, явные патогенные свойства золотистого стафилококка проявляются не всегда. Он может длительное время «мирно» сосуществовать на коже, слизистых оболочках, в кишечнике и во влагалище у женщин. По статистике, около 40% людей являются бессимптомными носителями этого микроорганизма.
Известно почти 120 заболеваний, вызванных золотистым стафилококком. Наиболее часто такие заболевания встречаются у детей до одного года и у людей с ослабленным иммунитетом. Золотистый стафилококк занимает лидирующие позиции среди возбудителей госпитальных инфекций.
| Симптом | Возможная локализация инфекции | Метод диагностики |
|---|---|---|
| Нагноение ран, абсцессы | Кожа, мягкие ткани | Микроскопия, посев на питательные среды |
| Пневмония | Легкие | Рентгенография грудной клетки, посев мокроты |
| Эндокардит | Сердце | Эхокардиография, посев крови |
| Токсический шоковый синдром | Системное поражение | Анализ крови, посев крови |
| Пищевое отравление | Желудочно-кишечный тракт | Анализ кала, рвотных масс |
| Конъюнктивит | Глаза | Микроскопия конъюнктивального соскоба |
| Остеомиелит | Кости | Рентгенография, КТ, МРТ, посев костного материала |
| Сепсис | Кровь, различные органы | Анализ крови, посев крови, исследование различных биологических материалов |
ПУТИ ЗАРАЖЕНИЯ
Заражение стафилококковой инфекцией может произойти от больного человека или от носителя бактерий.
Золотистый стафилококк — это бактерия, о которой часто говорят в медицинских кругах и среди пациентов. Многие люди знают, что она может вызывать различные инфекции, от легких до серьезных. В социальных сетях можно встретить обсуждения о том, как важно соблюдать гигиену, чтобы избежать заражения. Некоторые делятся личным опытом, рассказывая о том, как долго лечились от инфекций, вызванных этой бактерией. Врачебные рекомендации также акцентируют внимание на необходимости своевременного обращения за медицинской помощью при первых симптомах. Однако, несмотря на страхи, многие отмечают, что при правильном лечении и профилактике можно успешно справиться с инфекцией. Важно помнить, что знание о стафилококке помогает людям быть более внимательными к своему здоровью.

Факторы риска стафилококковой инфекции:
- Повреждения кожи и слизистых: трещины, ссадины, проколы и другие.
- Игнорирование норм личной гигиены.
- Первичный или вторичный иммунодефицит, например, ВИЧ/СПИД.
- Рождение недоношенным.
- Длительное применение антибактериальных, гормональных или иммуносупрессивных препаратов.
- Негативное воздействие окружающей среды.
- Хронические заболевания, такие как диабет или патологии щитовидной железы.
- Острые и хронические инфекции, а также другие патологические состояния.
СИМПТОМЫ
Проявления инфекции, вызванной золотистым стафилококком, зависят от места проникновения микроба, его агрессивности и состояния иммунной системы пациента.
Золотистый стафилококк может поражать практически все ткани организма — от кожи до брюшной полости и внутренних органов. Он также способен вызывать общее заражение крови.

Самые распространенные заболевания, вызванные S. aureus:
- Различные гнойные заболевания кожи называются пиодермиями. В зависимости от глубины воспалительного процесса выделяют фолликулиты, фурункулы, карбункулы, абсцессы и флегмоны.
- Гнойный мастит наблюдается у женщин, кормящих грудью.
- Поражения верхних дыхательных путей включают ринит, синусит, фарингит, ларингит и другие. Основным признаком наличия золотистого стафилококка в этих случаях является гнойное отделяемое из носоглотки.
- Бронхиты, пневмонии и плевриты. Пневмония, вызванная стафилококком, протекает особенно тяжело. Явно выражены симптомы интоксикации и боль в грудной клетке, так как часто вовлекается плевра. Характерно образование гнойных очагов (абсцессов) в легких, которые могут прорываться в плевральную полость, что приводит к эмпиеме.
- Этот микроорганизм является основной причиной гнойных заболеваний опорно-двигательного аппарата, таких как остеомиелит и артрит. Эти состояния чаще всего развиваются у подростков. У взрослых стафилококковые артриты нередко возникают на фоне ревматизма или после установки суставных протезов.
- Поражение внутренней оболочки сердца, известное как эндокардит, встречается примерно у 10% пациентов с бактериемией. В этом случае быстро происходит разрушение сердечных клапанов, что приводит к серьезным осложнениям и высокой вероятности летального исхода.
- Токсины, вырабатываемые золотистым стафилококком, могут вызывать тяжелые интоксикации организма, включая пищевые отравления, синдром токсического шока и другие состояния.
- Первые признаки пищевого отравления, вызванного золотистым стафилококком, обычно проявляются через несколько часов после употребления зараженной пищи. У пациента возникают тошнота, рвота, спастические боли в животе и водянистый стул. Как правило, эти симптомы проходят самостоятельно в течение суток.
ДИАГНОСТИКА
Утверждать, что это золотистый стафилококк, основываясь только на клинических симптомах, невозможно, так как проявления инфекции не являются специфичными.
Для точного диагноза необходимо провести бактериологический посев образцов из пораженных участков и выполнить микроскопическое исследование. В ходе анализа также определяется чувствительность бактерий к различным антибактериальным препаратам.
На питательных средах золотистый стафилококк образует гладкие, выпуклые мутноватые колонии диаметром около 4–5 мм. Эти колонии имеют различные оттенки желтого цвета, что и стало причиной их названия.
ЛЕЧЕНИЕ
Принципы лечения золотистого стафилококка:
- Подавление роста микроба осуществляется с помощью различных антибактериальных препаратов и стафилококковых бактериофагов.
- Основу лечения составляют антибактериальные средства. Рекомендуется использовать антибиотики, к которым чувствителен конкретный штамм золотистого стафилококка.
- Наиболее часто применяются препараты из группы пенициллинов (полусинтетические, комбинированные с клавулановой кислотой и др.). Также активно используются аминогликозиды, фторхинолоны, макролиды, тетрациклины и другие.
- Местное лечение антибактериальными средствами в виде мазей, кремов, примочек и т. п. обязательно. Обычно такие процедуры назначаются после хирургической санации инфекционных очагов и удаления гнойного содержимого.
- Коррекция иммунного статуса осуществляется с помощью иммуномодуляторов, антиоксидантов, витаминных комплексов и др.
- Для специфической иммунотерапии применяются антистафилококковые иммуноглобулины и плазма.
- Необходимо проводить полноценное лечение сопутствующих заболеваний, которые могут снижать реактивность организма.
Избавиться от золотистого стафилококка — задача сложная. Этот микроб быстро развивает устойчивость к многим антибактериальным препаратам из-за бесконтрольного использования антибиотиков в ненужных ситуациях.
Важно помнить, что антибактериальное лечение стафилококковой инфекции должно проводиться только при наличии клинических проявлений. «Положительный» анализ на золотистый стафилококк у внешне здорового человека не является основанием для назначения антибиотиков.
ОСЛОЖНЕНИЯ
Основным осложнением, вызванным золотистым стафилококком, является образование гнойных очагов в различных частях тела. Проникновение этого микроорганизма в системный кровоток может вызвать серьезные состояния, угрожающие здоровью и жизни, такие как сепсис, эндокардит и менингит.
Например, если гнойничковые образования появляются на коже лица, золотистый стафилококк может попасть в мозговые оболочки и мозг через кровоток, что приведет к менингиту или абсцессу мозга.
ПРОФИЛАКТИКА
Ключевым аспектом предотвращения стафилококковой инфекции является укрепление неспецифического иммунитета. Для этого необходимо вести здоровый образ жизни, соблюдать гигиенические нормы, правильно питаться и избегать вредных привычек.
Кроме того, важно своевременно выявлять и лечить любые соматические и инфекционные заболевания.
ПРОГНОЗ НА ВЫЗДОРОВЛЕНИЕ
Прогноз заболевания во многом зависит от местоположения инфекционного очага, тяжести недуга и эффективности лечения.
При легких поражениях кожи и слизистых оболочек прогноз обычно положительный. Однако при развитии бактериемии и вовлечении внутренних органов он значительно ухудшается, так как более 50% таких случаев могут закончиться летальным исходом.
Вопрос-ответ
Чем опасен стафилококк золотистый?
Помимо кожных проявлений золотистый стафилококк также может вызывать инфекции других органов и систем. Например, он может проникнуть в органы дыхательной системы, вызывая пневмонию.
Чем вылечить золотистый стафилококк?
Для лечения стафилококковой инфекции применяют антибиотики нового поколения — полусинтетические пенициллины, аминогликозиды и некоторые другие. Также используют бактериофаги — специфические вирусы, которые прицельно уничтожают именно стафилококки.
Какие симптомы при стафилококке?
Симптомы стафилококковой инфекции могут варьироваться в зависимости от типа инфекции, но часто включают покраснение, отек и боль в области поражения, гнойные выделения, лихорадку, озноб и общее недомогание. В случае более серьезных инфекций, таких как пневмония или сепсис, могут наблюдаться затрудненное дыхание, высокая температура и резкое ухудшение состояния.
Советы
СОВЕТ №1
Регулярно мойте руки с мылом, особенно перед едой и после посещения общественных мест. Это поможет снизить риск заражения золотистым стафилококком, который может передаваться через контакт с зараженными поверхностями.
СОВЕТ №2
Следите за состоянием своей кожи и немедленно обрабатывайте любые порезы или ссадины антисептиком. Золотистый стафилококк может проникать в организм через открытые раны, поэтому важно поддерживать их в чистоте и защищать от инфекции.
СОВЕТ №3
Избегайте использования чужих личных вещей, таких как полотенца, бритвы или косметические принадлежности. Это поможет предотвратить передачу бактерий и снизит риск заражения.
СОВЕТ №4
Если у вас есть подозрение на инфекцию, вызванную золотистым стафилококком, не откладывайте визит к врачу. Раннее обращение за медицинской помощью может предотвратить развитие серьезных осложнений.